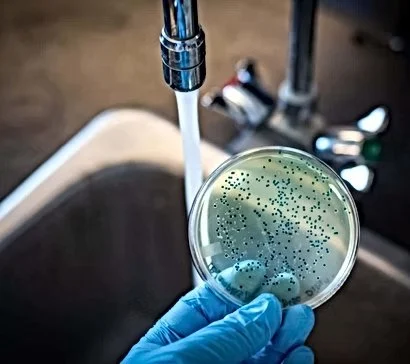
How to Test for Bacteria in Household Water Supply

- 1. Why Testing for Bacteria in Your Water is Important
- 2. Common Types of Bacteria Found in Household Water
- 3. How to Test for Bacteria in Your Household Water
- 4. Interpreting the Results of Your Water Test
- 5. Solutions for Contaminated Water: How to Fix the Problem
- 6. Finding Professional Help: A Recommendation from Plumbers Supply Hub
1. Why Testing for Bacteria in Your Water is Important
Testing for bacteria in your household water supply is essential for ensuring the safety and health of you and your family. Bacteria in water can lead to serious health issues, such as gastrointestinal problems, skin infections, and even more severe conditions. Drinking contaminated water or using it for cooking and bathing can cause illness, so regular testing is crucial to prevent these risks. If you live in an area with private wells or older plumbing systems, testing for bacteria becomes even more critical, as these water sources may be more vulnerable to contamination.
2. Common Types of Bacteria Found in Household Water
Several types of bacteria can contaminate your household water supply, and it’s important to know which ones to look out for:
2.1 Coliform Bacteria
Coliform bacteria are the most common indicator of contamination in household water. While not all coliform bacteria are harmful, the presence of coliforms suggests that harmful pathogens, such as E. coli, could also be present. These bacteria are typically found in the intestines of humans and animals, and their presence in water suggests that the water may have been contaminated with fecal matter.
2.2 E. coli (Escherichia coli)
E. coli is a type of coliform bacteria that can cause severe food poisoning. It is commonly associated with contaminated water sources, especially those exposed to human or animal waste. Ingesting water contaminated with E. coli can lead to symptoms such as diarrhea, abdominal cramps, and vomiting.
2.3 Legionella
Legionella bacteria thrive in warm water, such as in hot tubs, cooling towers, or water heaters. These bacteria can cause Legionnaires' disease, a severe form of pneumonia. While less common than coliform or E. coli, Legionella contamination is particularly dangerous in places where the water temperature is kept warm.
3. How to Test for Bacteria in Your Household Water
There are a few ways to test for bacteria in your water, and choosing the right method depends on the type of testing you prefer and the resources available to you:
3.1 At-Home Test Kits
At-home test kits are widely available and easy to use. These kits typically involve taking a water sample and placing it in a testing container with special reagents. After a few hours, the kit will indicate whether the sample contains bacteria. These tests are convenient and can be performed quickly, but they may not be as comprehensive as professional testing methods.
3.2 Laboratory Testing
For a more accurate and detailed analysis, you can send a water sample to a certified laboratory for testing. Laboratories will test for specific bacteria and other contaminants, providing you with a comprehensive report on your water quality. Laboratory testing is recommended if you want a more thorough examination or if you have reason to believe that your water may be contaminated with harmful pathogens.
3.3 Water Testing Services
Professional water testing services offer an in-depth analysis of your household water supply. These services often include the collection of water samples and an on-site visit by experts who will perform the necessary tests. Many plumbing companies offer water testing services, and they can help you identify the presence of bacteria, as well as recommend solutions if contamination is found.
4. Interpreting the Results of Your Water Test
Once you have tested your water, it’s important to understand the results. Different bacteria require different thresholds for concern. Here’s what you should look for in your test results:
4.1 Coliform Bacteria
If the test shows the presence of coliform bacteria, it’s an indication that harmful pathogens may be present in your water. A positive result means that the water is not safe to drink without further treatment.
4.2 E. coli
A positive result for E. coli is a serious concern and should be addressed immediately. E. coli contamination means that your water has been exposed to human or animal waste, and drinking it could lead to severe health issues. Immediate treatment is necessary.
4.3 Legionella
If Legionella bacteria are detected, it’s essential to take action to reduce the risk of Legionnaires’ disease. This may involve cleaning and disinfecting your water system, especially in areas with warm water, such as water heaters or hot tubs.
5. Solutions for Contaminated Water: How to Fix the Problem
If your water tests positive for bacteria, there are several solutions you can consider to treat the contamination:
5.1 Boiling Water
Boiling your water for at least one minute is one of the most effective ways to kill harmful bacteria, including E. coli and coliforms. If you have a temporary issue with your water supply, boiling water can be a short-term solution until you address the problem more permanently.
5.2 Installing Water Filtration Systems
A high-quality water filtration system can remove bacteria and other contaminants from your water supply. Filtration systems are available for point-of-use applications (such as under-sink filters) or whole-house filtration systems that treat all the water coming into your home.
5.3 Chlorination
Chlorinating your water supply is a common method used to disinfect well water or other water sources that may be contaminated with bacteria. Chlorination effectively kills bacteria, but it requires regular monitoring to ensure the proper levels are maintained.
6. Finding Professional Help: A Recommendation from Plumbers Supply Hub
If you are concerned about the safety of your water, or if you need help testing for bacteria and treating your water, visit Plumbers Supply Hub. We provide a wide range of plumbing services, including water testing and filtration system installations. Our network of licensed professionals can help ensure your water is clean, safe, and free from harmful bacteria. Visit us today to find the best solutions for your water quality needs.









Flo Maxx Sewer & Plumbing Inc.4.0 (237 reviews)
Your Second Opinion Plumbing Co.5.0 (191 reviews)
Chuck Ollinger Plumbing, Heating & Cooling4.0 (36 reviews)
Campbell Plumbing & Drain Cleaning4.0 (93 reviews)
Universal Plumbers4.0 (8 reviews)
Redondo beach, JRS Plumbing5.0 (2 reviews)
How to Install a New Showerhead: A Step-by-Step DIY Plumbing Guide
How to Handle Plumbing Emergencies When You’re Away from Home
How to Replace a Broken Pipe in a Slab Foundation: Step-by-Step Guide
How to Repair a Pipe Saddle That Leaks
How to Replace a Sprinkler System Backflow Valve
How to Test Water Pressure at Multiple Fixtures